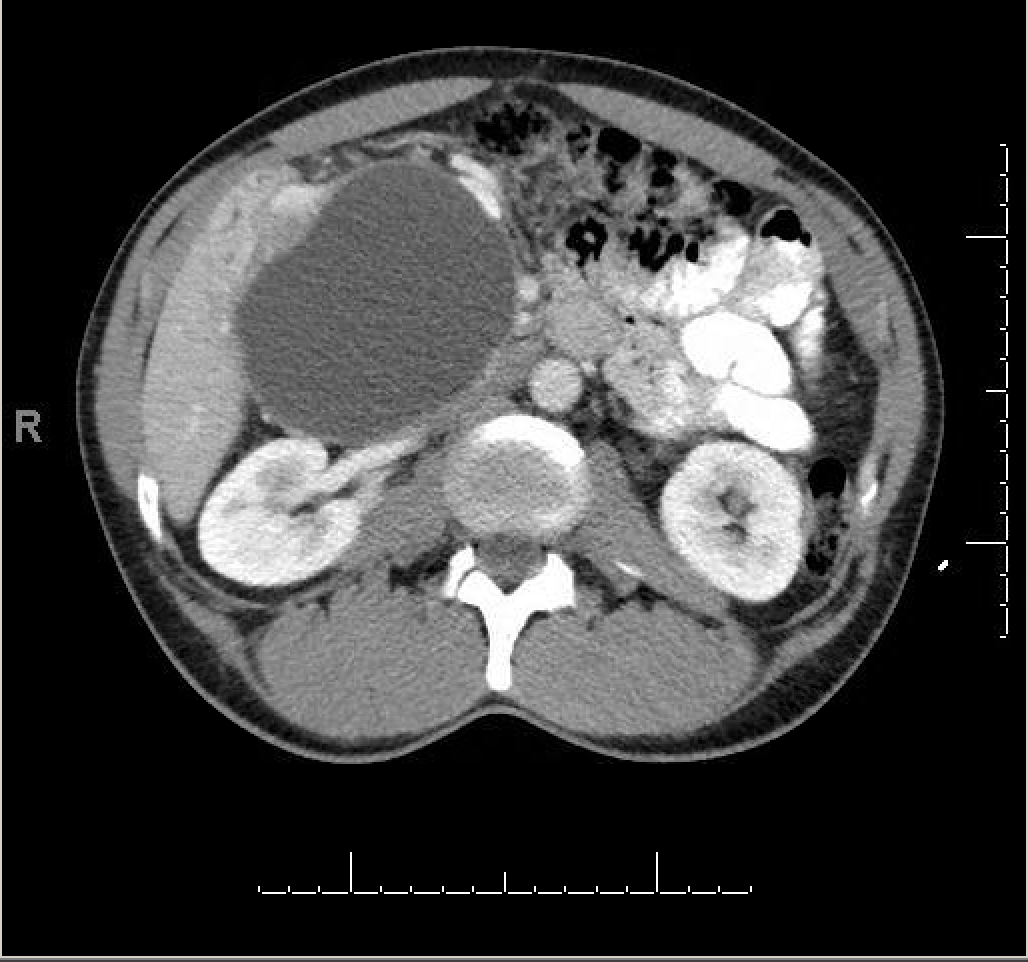
Mass in syncope CT

A 52-year-old female with no significant past medical history presented to our ED for evaluation of syncope. The episode occurred at work while she was sitting down. There was a prodrome of spots in her vision and lightheadedness. She had loss of consciousness for a few seconds, and there was no reported seizure-like activity or post-ictal state. She reported that she had been feeling well before and after the event. She denied a history of previous syncope, chest pain, shortness of breath, abdominal pain, vomiting, diarrhea, blood in the stool, and vaginal bleeding. There was no family history of cardiac disorders.
Initial VS: HR 90, BP 119/79, RR 20, SpO2 98% on RA, T 36.5 °C
An ECG, seen below, was obtained that showed normal sinus rhythm with normal intervals and no ectopy.
A bedside cardiac ultrasound was performed as part of the work-up as is often done in our ED when a patient presents with syncope.
Here is the para-sternal long view:
Here is the para-sternal short view:
Here is the apical 4-chamber view:
All of the above images were interpreted as within normal limits. Then a subcostal 4-chamber view was obtained:
The heart still appeared normal, but something caught the eye of the sonographer:
This was investigated more:
There is a homogenous mass seen adjacent to the liver, compressing the IVC.
Could the cause of her syncope be obstruction of venous return to the heart?
The providers were unsure. A CT scan of the abdomen was obtained to better define the mass. Here are some of the images:
The mass was thought to be either a large pancreatic pseudocyst, a low-grade cystic pancreatic neoplasm, or a duodenal duplication cyst.
The patient was admitted for further work-up given that she stated that she would not follow-up as an outpatient. She unfortunately eloped from the hospital shortly after admission. She presented to ED in cardiac arrest about 1 month later and was unable to be resuscitated. The cause of the arrest was unknown.
No autopsy was performed.
What do you think it is?

Is the septum hypertrophic on the PSL? LV outflow tract obstruction?